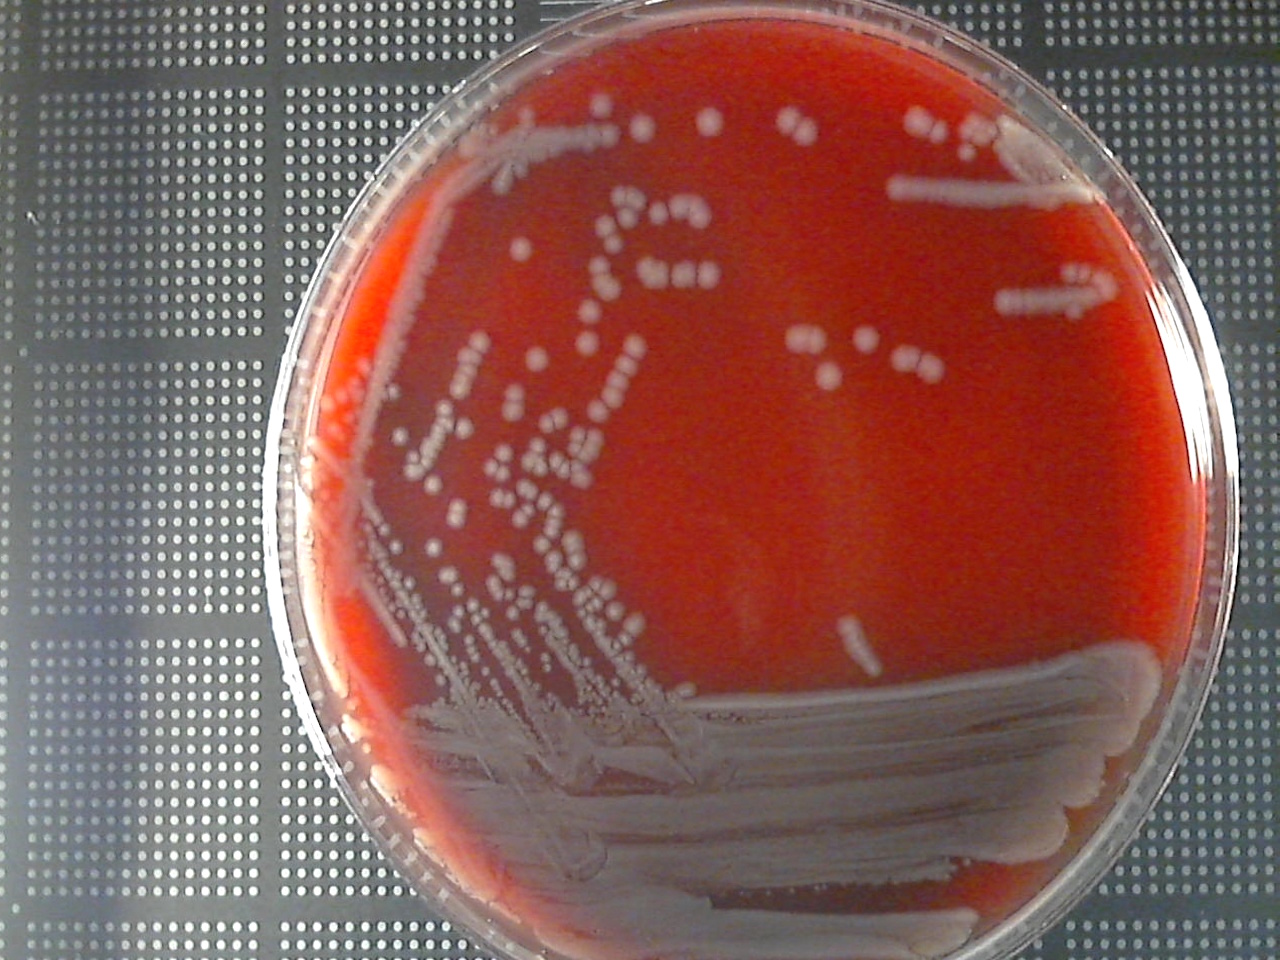
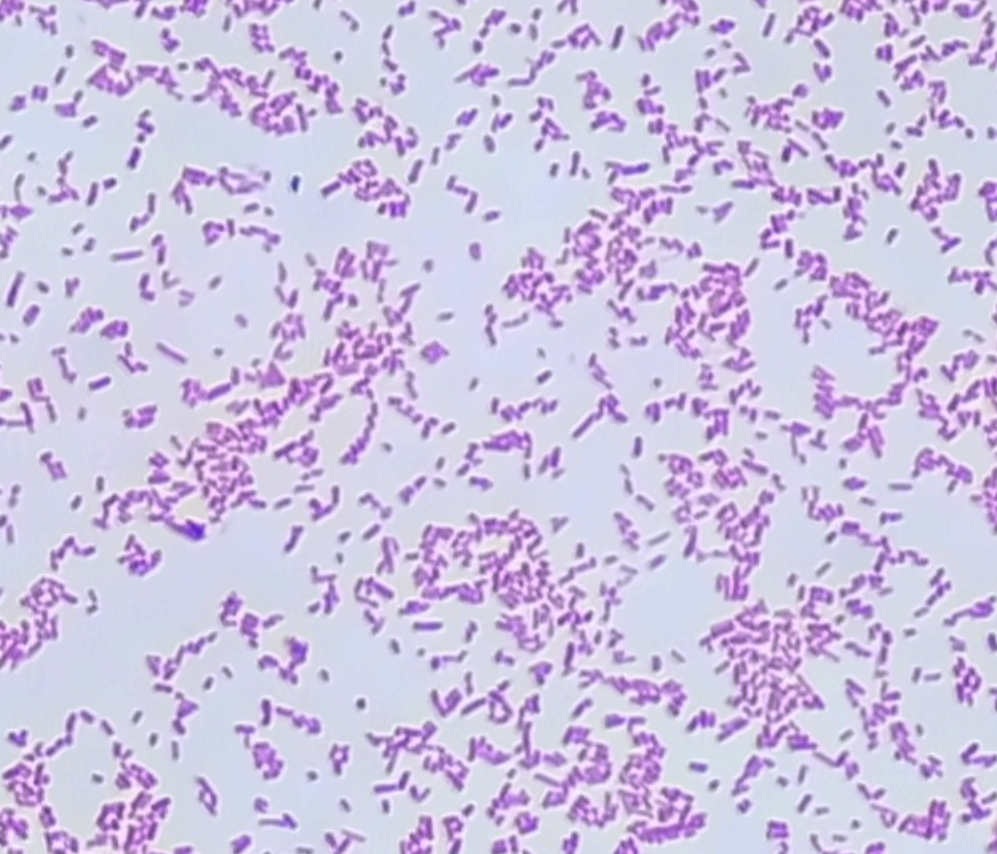

Salmonella
Salmonella enteridis

Incubation: Aerobic
Media: SBA
Source: Stool
Colony Morphology
Form: Round
Elevation: Raised
Margin: Entire
Color: Gray
Hemolysis — Gamma/None
Gram Stain
Gram Negative
Microscopic Morphology: Bacilli
Organism Size: Medium
Testing Pathways
Oxidase: Negative
Lactose Fermenter? No
Oxidation-Fermentation (OF) Test: Fermenter
Motility: Positive
TSI: K/A+-
Indole: Negative
Urease Production: Negative